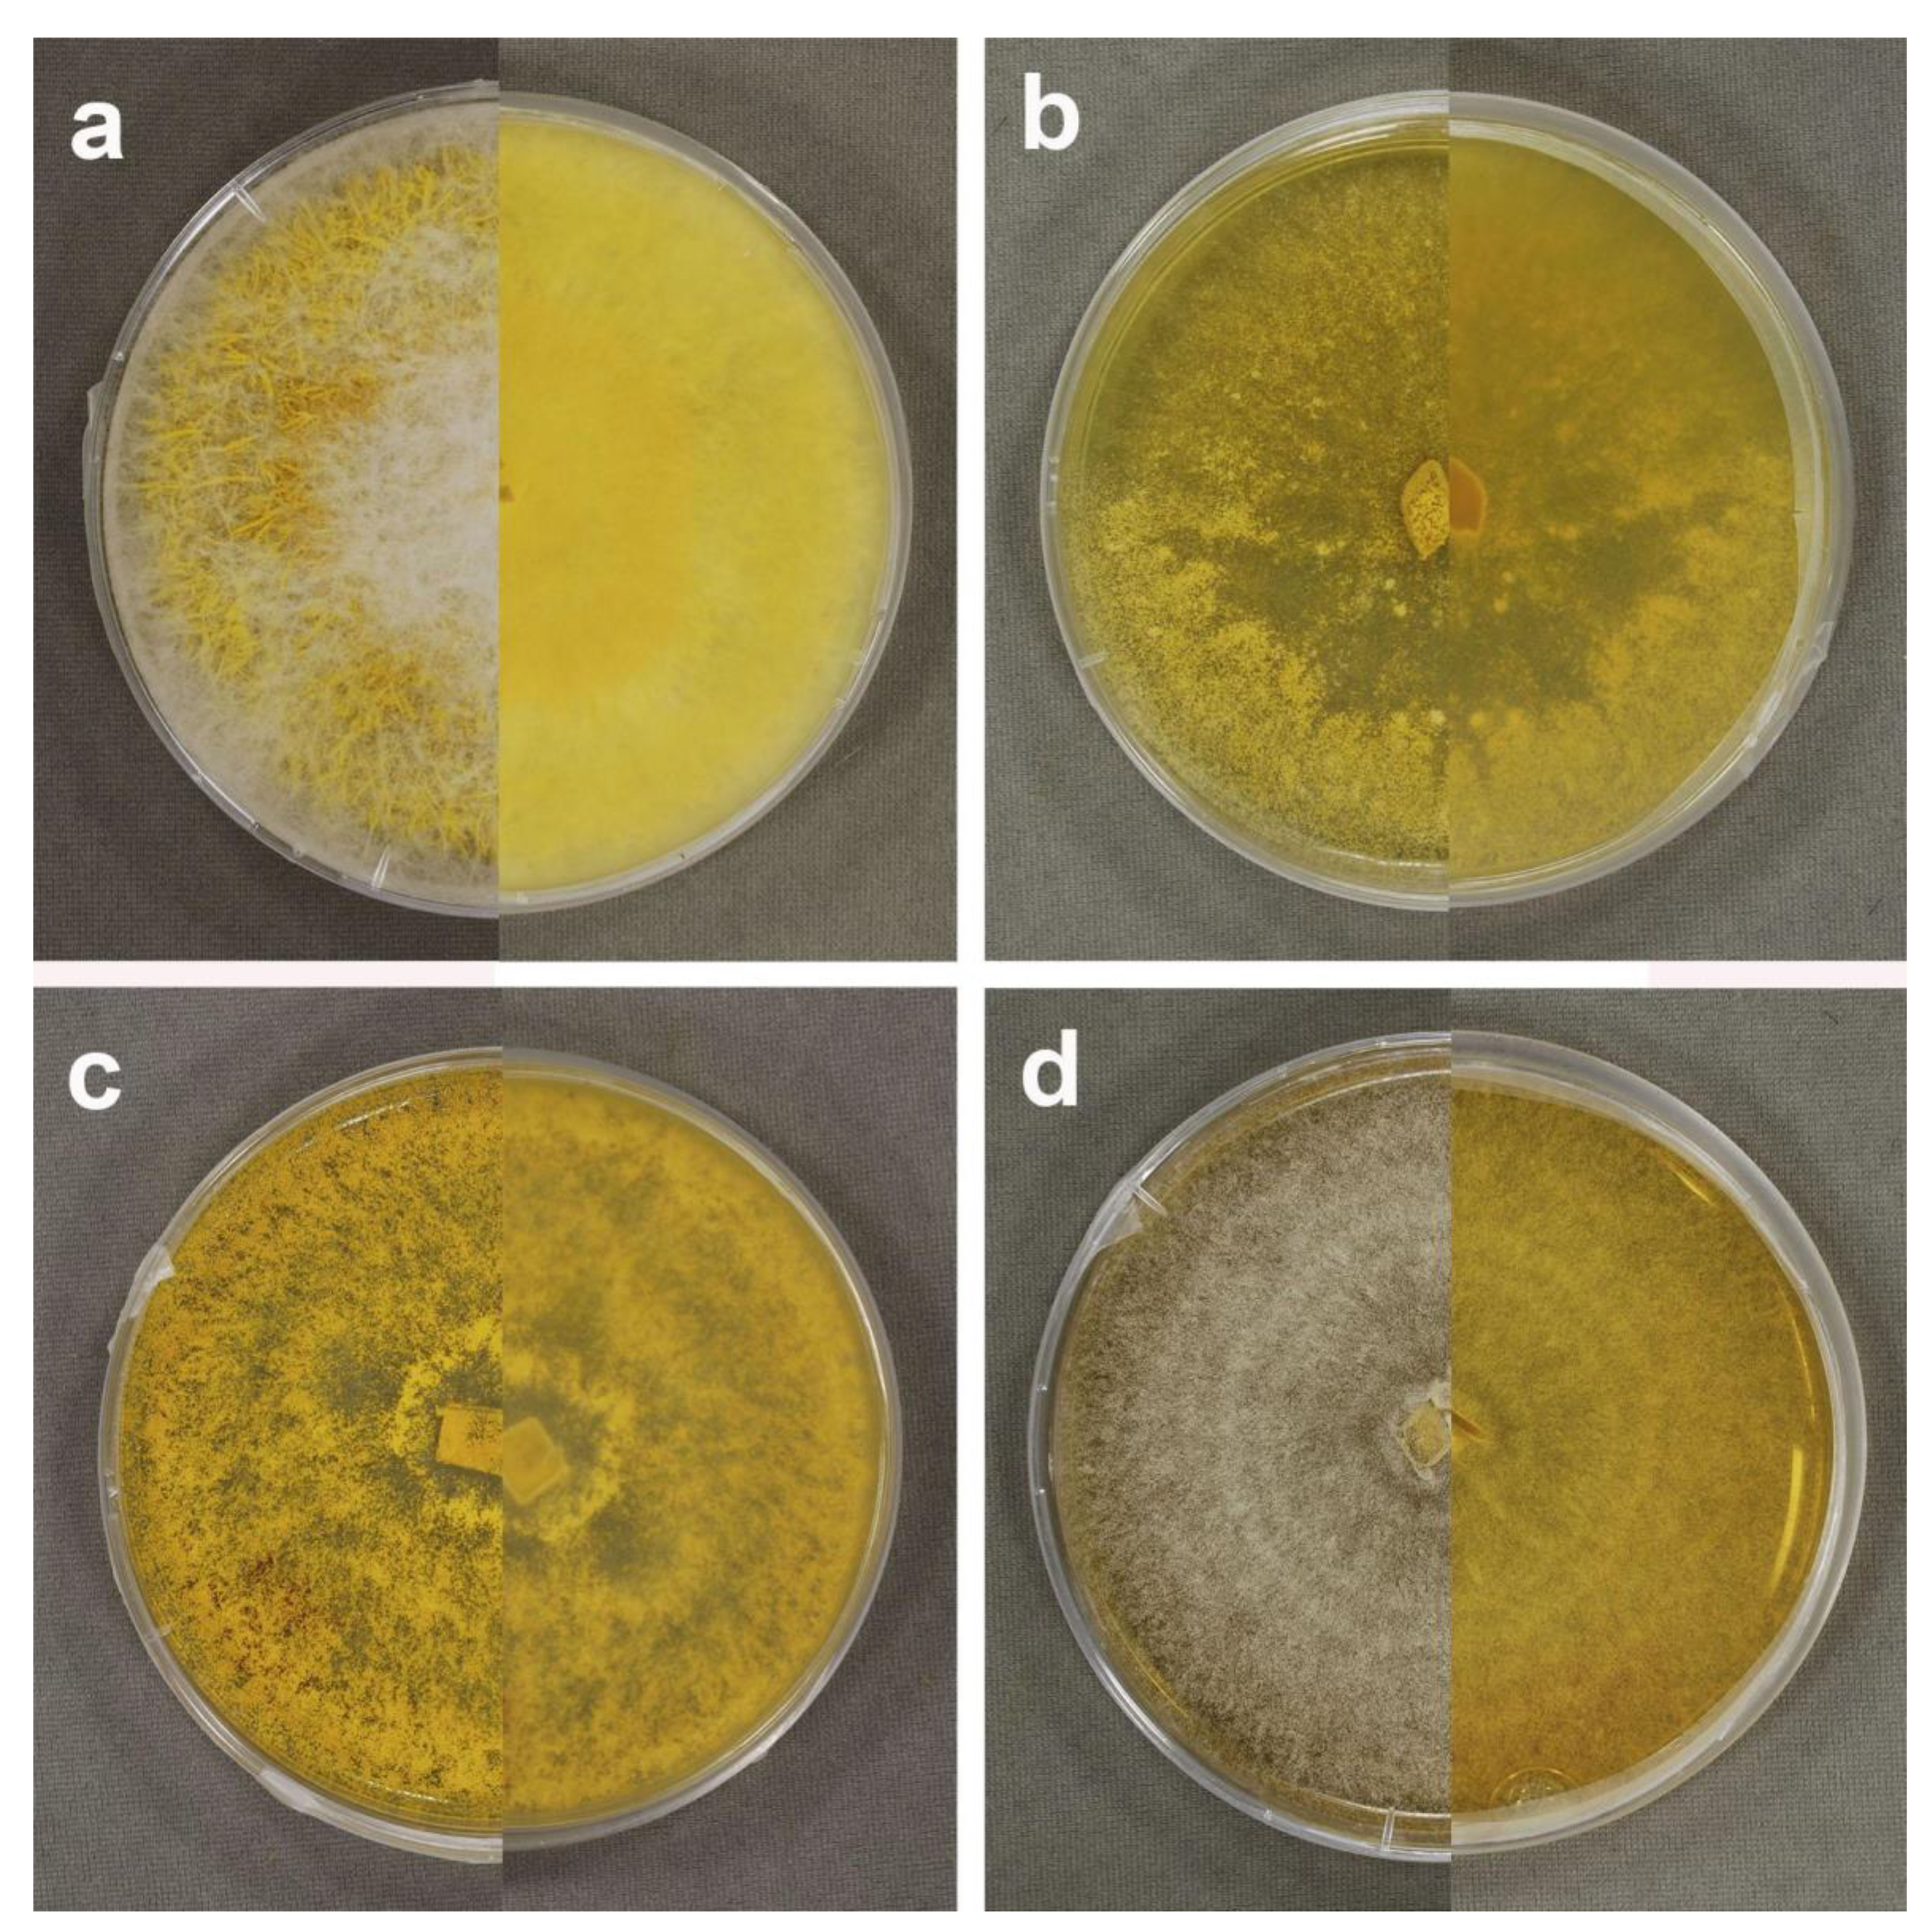
Microorganisms 09 02261 g007

Diversity and Host Relationships of the Mycoparasite Sepedonium (Hypocreales, Ascomycota) in Temperate Central Chile
Abstract
1. Introduction
2. Materials and Methods
2.1. Study Area and Material Collection
2.2. Host Species
2.3. Strain Cultivation
2.4. Taxonomic Analysis
2.4.1. Optical Microscopy
2.4.2. Scanning Electron Microscopy
2.4.3. DNA Extraction
2.4.4. PCR Amplification and Sequencing
2.4.5. Sequence Processing and Phylogenetic Analysis
3. Results
3.1. Taxonomy of Sepedonium Strains and Host Taxa
3.2. Phylogenetic Characterization of Sepedonium Strains
3.3. Morphological Characterization of Sepedonium spp.
3.4. Host Specificity and Frequency
3.5. Keys for Sepedonium spp.
| 1 Aleurioconidia subcylindrical, spindle-shaped or ellipsoid, finely warty or longitudinally grooved | 2 |
| 1* Aleurioconidia globose, covered with prominent warts (sea-mine-shaped) | 3 |
| 2 Aleurioconidia ellipsoid, greyish brown, finely warty to smooth | S. tulasneanum |
| 2* Aleurioconidia subcylindrical to spindle-shaped, yellow, longitudinally grooved | S. chlorinum |
| 3 Phialoconidia lecythiform, in Chile on allochthonous hosts | S. ampullosporum |
| 3* Phialoconidia oval or ellipsoid, in Chile on allochthonous or native hosts | 4 |
| 4 Phialids rarely over 60 µm long, only exceptionally reaching 100µm | 5 |
| 4* Few or most phialids over 100 µm long | 7 |
| 5 Mature aleurioconidia 8–14 µm in diam., with angular warts, on Xerocomus chrysenteron and related species | S. microspermum |
| 5* Mature aleurioconidia ≥15 µm in diam., warts cylindrical, barrel- or amphora-shaped, on different hosts | 6 |
| 6 Phialids up to 8 per verticill, L/W of phialoconidia up to 3, on Chalciporus piperatus | S. chalcipori |
| 6* Phialids up to 3 (4) per verticill, L/W of phialoconidia up to 4.3, on native Chilean Boletacean hosts | S. loyorumsp. nov. |
| 7 Aleurioconida brownish, on | Suillus pictus S. brunneum |
| 7* Aleurioconidia yellow | 8 |
| 8 Phialids up to 120 µm long, colonies slowly growing, up to 5 mm/day in MPA | S. chrysospermum |
| 8* Phialids up to 250 µm long, colonies fast-growing, up to 8 mm/day in MPA | S. laevigatum |
| 1 Plate surface after few days covered by abundant and cottony to stringy aerial mycelium | S. ampullosporum |
| 1* Plate surface remaining tomentose to grainy or almost smooth, with little or no aerial mycelium | 2 |
| 2 Colony surface lastingly grayish-white, only slowly turning yellowish | S. loyorum sp. nov. |
| 2* Colony surface after few days turning intensive golden yellow | 3 |
| 3 Colony fast-growing, reaching the border of the plate after about one week, surface deep golden yellow, becoming almost orange | S. laevigatum |
| 3* Colony slow-growing, reaching the border of the plate after about two weeks | S. chrysospermum |
4. Discussion
4.1. Regional Diversity and Frequency of Sepedonium spp.
4.2. Phylogenetic Kinship of S. loyorum sp. nov.
4.3. Biogeographical Aspects of Sepedonium in Chile
4.4. Sepedonium-Resistant Boletales
4.5. Trophic Connections and Specificity within Parasite-Host Guilds: Invasive vs. Endemic Taxa
4.6. Conservation Criteria for Sepedonium on Threatened Hosts
Supplementary Materials
Author Contributions
Funding
Institutional Review Board Statement
Informed Consent Statement
Data Availability Statement
Acknowledgments
Conflicts of Interest
References
- Neuhof, T.; Berg, A.; Besl, H.; Schwecke, T.; Dieckmann, R.; von Döhren, H. Peptaibol Production bySepedonium Strains Parasitizing Boletales. Chem. Biodivers. 2007, 4, 1103–1115. [Google Scholar] [CrossRef]
- Yurkov, A.; Krüger, D.; Begerow, D.; Arnold, N.; Tarkka, T. Basidiomycetous yeasts from Boletales fruiting bodies and their interactions with the mycoparasite Sepedonium chrysospermum and the host fungus Paxillus. Microb. Ecol. 2012, 63, 295–303. [Google Scholar] [CrossRef]
- Otto, A.; Laub, A.; Wendt, L.; Porzel, A.; Schmidt, J.; Palfner, G.; Becerra, J.; Krüger, D.; Stadler, M.; Wessjohann, L.; et al. Chilenopeptins A and B, Peptaibols from the Chilean Sepedonium aff. chalcipori KSH 883. J. Nat. Prod. 2016, 79, 929–938. [Google Scholar] [CrossRef]
- Otto, A.; Laub, A.; Haid, M.; Porzel, A.; Schmidt, J.; Wessjohann, L.A.; Arnold, N. Tulasporins A–D, 19-Residue Peptaibols from the Mycoparasitic Fungus Sepedonium tulasneanum. Nat. Prod. Commun. 2016, 11, 1821–1824. [Google Scholar] [CrossRef]
- Vinale, F.; Sivasithamparam, K.; Ghisalberti, E.L.; Woo, S.L.; Nigro, M.; Marra, R.; Lombardi, N.; Pascale, A.; Ruocco, M.; Lanzuise, S.; et al. Trichoderma Secondary Metabolites Active on Plants and Fungal Pathogens. Open Mycol. J. 2014, 8, 127–139. [Google Scholar] [CrossRef]
- Helfer, W. Pilze auf Pilzfruchtkörpern: Untersuchungen zur Ökologie, Systematik und Chemie; IHW-Verlag: Eching, Germany, 1991; p. 211. ISBN 3980273229. [Google Scholar]
- Mitova, M.; Murphy, A.; Lang, J.; Blunt, A.; Cole, G.; Munro, M. Evolving trends in the dereplication of natural product extracts. The isolation of chrysaibol, an antibiotic peptaibol from a New Zealand sample of the mycoparasitic fungus Sepedonium chrysospermum. J. Nat. Prod. 2008, 71, 1600–1603. [Google Scholar] [CrossRef]
- Sahr, T.; Ammer, H.; Besl, H.; Fischer, M. Infrageneric classification of the boleticolous genus Sepedonium: Species delimitation and phylogenetic relationships. Mycologia 1999, 91, 935–943. [Google Scholar] [CrossRef]
- Damon, S.C. Two noteworthy species of Sepedonium. Mycologia 1952, 44, 86–96. [Google Scholar] [CrossRef]
- Montes, B.; Restrepo, A.; McEwen, J.G. Nuevos aspectos sobre la clasificación de los hongos y su posible aplicación médica. Biomedica 2003, 23, 213–224. [Google Scholar] [CrossRef] [PubMed][Green Version]
- Binder, M.; Hibbett, D. Molecular systematics and biological diversification of Boletales. Mycologia 2006, 98, 971–981. [Google Scholar] [CrossRef] [PubMed]
- Espinosa, M. Informe de encargado de la sección plantas criptógamas. Boletín del Museo Nac. de Hist. Nat. Chile 1917, 10, 186–187. [Google Scholar]
- Garrido, N. Agaricales s.l. und ihre Mykorrhizen in den Nothofagus-Wäldern Mittelchiles; Bibliotheca Mycologica 120; J. Cramer: Berlin/Stuttgart, Germany, 1988; p. 528. ISBN 3-443-59021-7. [Google Scholar]
- Cowling, R.M.; Rundel, P.W.; Lamont, B.B.; Arroyo, M.K.; Arianoutsou, M. Plant diversity in Mediterranean-climate regions. Trends Ecol. Evol. 1996, 11, 362–366. [Google Scholar] [CrossRef]
- Ramírez, C.; San Martín, C. Diversidad de macrófitos Chilenos. In Macrófitas y Vertebrados de los Sistemas Límnicos de Chile; Vila, I., Veloso, A., Schlatter, R., Ramírez, C., Eds.; Editorial Universitaria: Santiago, Chile, 2005; pp. 21–61. ISBN 9561118513. [Google Scholar]
- Valdovinos, C. Invertebrados dulceacuícolas, Diversidad de especies. In Biodiversidad de Chile: Patrimonios y Desafíos; CONAMA: Santiago, Chile, 2006; pp. 202–223. ISBN 956-8018-22-0. [Google Scholar]
- Habit, E.; Dyer, B.; Vila, I. Estado de conocimiento de los peces dulceacuícolas de Chile. Gayana 2006, 70, 100–113. [Google Scholar] [CrossRef]
- Vidal, M.A. Biogeografía de anfibios y reptiles. In Herpetología de Chile; Vidal, M.A., Labra, A., Eds.; Science Verlag: Santiago, Chile, 2008; pp. 195–231. ISBN 9563194209. [Google Scholar]
- Vila, I.; Habit, E. Current situation of the fish fauna in the Mediterranean region of Andean river systems in Chile. Fishes Mediterr. Environ. 2015, 2, 1–19. [Google Scholar] [CrossRef]
- Fierro, P.; Valdovinos, C.; Arismendi, I.; Díaz, G.; De Gamboa, M.R.; Arriagada, L. Assessment of anthropogenic threats to Chilean Mediterranean freshwater ecosystems: Literature review and expert opinions. Environ. Impact Assess. Rev. 2019, 77, 114–121. [Google Scholar] [CrossRef]
- Nouhra, E.R.; Palfner, G.; Kuhar, F.; Pastor, N.; Smith, M.E. Ectomycorrhizal Fungi in South America: Their Diversity in Past, Present and Future Research. In Mycorrhizal Fungi in South America; Pagano, M.C., Lugo, M.A., Eds.; Springer: Berlin/Heidelberg, Germany, 2019; pp. 73–95. ISBN 978-3-030-15228-4. [Google Scholar]
- Horak, E. New and rare boletes from Chile. Boletín de la Soc. Argent. de Botánica 1977, 18, 97–109. [Google Scholar]
- Garrido, N. Survey of ectomycorrhizal fungi associated with exotic forest trees in Chile. Nova Hedwigia 1986, 43, 423–442. [Google Scholar]
- Palfner, G.; Casanova-Katny, M.A. Micocenosis en remanentes de bosque nativo y en plantaciones forestales en la Península de Arauco, Biobío, Chile: Composición, aspectos funcionales y conservación. In Biodiversidad y Ecología de los Bosques Costeros de Chile; Smith-Ramírez, C., Squeo, F.A., Eds.; Editorial Universidad de Los Lagos: Osorno, Chile, 2019; pp. 175–210. ISBN 978-956-6043-01-0. [Google Scholar]
- Fuentes, N.; Marticorena, A.; Saldaña, A.; Jerez, V.; Ortiz, J.C.; Victoriano, P.; Moreno, R.A.; Larraín, J.; Villaseñor-Parada, C.; Palfner, G.; et al. Multi-taxa inventory of naturalized species in Chile. NeoBiota 2020, 60, 25–41. [Google Scholar] [CrossRef]
- Horak, E. Agaricales y gasteromicetes secotioides. In Flora Criptogámica de Tierra del Fuego; Tomo XI, Fascículo 6: Fungi, Basidiomycetes; FECYC: Buenos Aires, Argentina, 1980; p. 524. [Google Scholar]
- Breitenbach, J.; Kränzlin, F. Boletes and Agarics. Fungi of Switzerland, 1st ed.; Editorial Mykologia: Lucerne, Switzerland, 1991; Volume 3, p. 361. ISBN 85604-230-X. [Google Scholar]
- Knudsen, H.; Vesterholt, J. Funga Nordica; Editorial Nordsvamp: Copenhague, Denmark, 2012; p. 511. ISBN 9788798396130. [Google Scholar]
- Lazo, W. Hongos de Chile, Atlas Micológico, 2nd ed.; Facultad de Ciencias, Universidad de Chile: Santiago, Chile, 2016; p. 316. ISBN 978-956-19-0959-5. [Google Scholar]
- White, T.J.; Bruns, T.D.; Lee, S.B.; Taylor, J.W. Amplification and direct sequencing of fungal ribosomal RNA genes for phylogenetics. In PCR Protocols, a Guide to Methods and Applications; Innis, M.A., Gelfand, D.H., Sninsky, J.J., White, T.J., Eds.; Academic Press: Cambridge, MA, USA, 1990; pp. 315–322. ISBN 0-12-372-180-6. [Google Scholar]
- Sullivan, R.; Bergen, M.S.; Patel, R.; Bills, G.F.; Alderman, S.C.; Spatafora, J.W.; White, J.R. Features and phylogenetic status of an enigmatic clavicipitalean fungus Neoclaviceps monostipa gen. et sp. nov. Mycologia 2001, 93, 90–99. [Google Scholar] [CrossRef]
- Crespo, A.; Lumbsch, H.T.; Mattsson, J.E.; Blanco, O.; Divakar, P.K.; Articus, K.; Wedin, M. Testing morphology-based hypotheses of phylogenetic relationships in Parmeliaceae (Ascomycota) using three ribosomal markers and the nuclear RPB1 gene. Mol. Phylogenet. Evol. 2007, 44, 812–824. [Google Scholar] [CrossRef] [PubMed]
- Edgar, R.C. MUSCLE: Multiple sequence alignment with high accuracy and high throughput. Nucleic Acids Res. 2004, 32, 1792–1797. [Google Scholar] [CrossRef] [PubMed]
- Xia, X. DAMBE5: A comprehensive software package for data analysis in molecular biology and evolution. Mol. Biol. Evol. 2013, 30, 1720–1728. [Google Scholar] [CrossRef] [PubMed]
- Darriba, D.; Taboada, G.L.; Doallo, R.; Posada, D. jModelTest 2: More models, new heuristics and parallelcomputing. Nat. Methods 2012, 9, 772. [Google Scholar] [CrossRef]
- Drummond, A.J.; Suchard, M.A.; Xie, D.; Rambaut, A. Bayesian phylogenetics with BEAUti and the BEAST1.7. Mol. Biol. Evol. 2012, 29, 1969–1973. [Google Scholar] [CrossRef]
- Degnan, J.H.; Rosenberg, N.A. Gene tree discordance, phylogenetic inference and the multispecies coalescent. Trends Ecol. Evol. 2009, 24, 332–340. [Google Scholar] [CrossRef]
- Rannala, B.; Yang, Z. Bayes estimation of species divergence times and ancestral population sizes using DNA sequences from multiple loci. Genetics 2003, 164, 1645–1656. [Google Scholar] [CrossRef] [PubMed]
- Rambaut, A.; Drummond, A.J.; Suchard, M. Tracer v1.6. 2013. Available online: http://tree.bio.ed.ac.uk/software/tracer/ (accessed on 8 October 2021).
- Rambaut, A. FigTree. Version 1.4.3. Program and Documentation. 2007. Available online: http://tree.bio.ed.ac.uk/software/figtree/ (accessed on 8 October 2021).
- Torbati, M.; Arzanlou, M.; Babai-Ahari, A. Polyphasic identification of Sepedonium microspermum isolated from two genera of Boletales in Iran. Mycol. Iran. 2018, 5, 71–77. [Google Scholar]
- Eldredge, N.; Cracraft, J. Phylogenetic Patterns and the Evolutionary Process; Columbia University Press: New York, NY, USA, 1980; pp. 92–93. ISBN 0 231 03802 X. [Google Scholar]
- Dickie, I.A.; Nuñez, M.A.; Pringle, A.; Lebel, T.; Tourtellot, S.G.; Johnston, P.R. Towards management of invasive ectomycorrhizal fungi. Biol. Invasions 2016, 18, 3383–3395. [Google Scholar] [CrossRef]
- Bresinsky, A.; Jarosch, M.; Fischer, M.; Schönberger, I.; Wittmann-Bresinsky, B. Phylogenetic Relationships within Paxillus s. I. (Basidiomycetes, Boletales): Separation of a Southern Hemisphere Genus. Plant Biol. 1999, 1, 327–333. [Google Scholar] [CrossRef]
- Kirk, P.M.; Cannon, P.F.; Minter, D.W.; Stalpers, J.A. Ainsworth and Bisby’s Dictionary of the Fungi, 10th ed.; International Mycological Institute, CAB International: Wallingford, UK, 2008; p. 771. ISBN 9780851998268. [Google Scholar]
- Vizzini, A.; Angelini, C.; Ercole, E. A new Neopaxillus species (Agaricomycetes) from the Dominican Republic and the status of Neopaxillus within the Agaricales. Mycologia 2012, 104, 138–147. [Google Scholar] [CrossRef] [PubMed]
- Bogaert, J.; Barima, Y.S.S.; Iyongo, L.; Mongo, W.; Bamba, I.; Mama, A.; Toyi, M.; Lafortezza, R. Forest Fragmentation: Causes, Ecological Impacts and Implications for Landscape Management. In Landscape Ecology in Forest Management and Conservation, Challenges and Solutions for Global Change; Li, C., Lafortezza, R., Chen, J., Eds.; Springer: Berlin, Germany, 2011; pp. 273–296. ISBN 978-3-642-12753-3. [Google Scholar]
- Echeverría, C.; Coomes, D.; Salas, J.; Rey-Benayasj, J.; Lara, M.; Newton, A. Rapid deforestation and fragmentation of Chilean temperate forests. Biol. Conserv. 2006, 130, 481–494. [Google Scholar] [CrossRef]
- Pliscoff, P. Aplicación de los Criterios de la Unión Internacional para la Conservación de la Naturaleza (IUCN) para la Evaluación de riesgo de los Ecosistemas Terrestres de Chile; Informe Técnico; Ministerio del Medio Ambiente: Santiago, Chile, 2015; p. 63. [Google Scholar]
- Luebert, F.; Pliscoff, P. Sinopsis Bioclimática y Vegetacional de Chile, 2nd ed.; Editorial Universitaria: Santiago, Chile, 2018; 384p, ISBN 9789561125759. ISSN 9789561125759. [Google Scholar]
- Carlson, C.J.; Hopkins, S.; Bell, K.C.; Doña, J.; Godfrey, S.S.; Kwak, M.L.; Lafferty, K.D.; Moir, M.L.; Speer, K.A.; Strona, G.; et al. A global parasite conservation plan. Biol. Conserv. 2020, 250, 108596. [Google Scholar] [CrossRef]

| S. ampullosporum | S. laevigatum | S. chrysospermum | S. loyorum | |
|---|---|---|---|---|
| Endemic hosts: | ||||
| Boletus loyita | 2 | |||
| Boletus loyo | 4 | |||
| Boletus putidus | 3 | |||
| Gastroboletus valdivianus | 3 | |||
| Allochthonous hosts: | ||||
| Chalciporus piperatus | 1 | |||
| Paxillus involutus | 2 | 9 | ||
| Rhizopogon roseolus | 1 | |||
| Rhizopogon luteolus | 1 | |||
| Suillus luteus | 6 | 1 | 1 | |
| Suillus granulatus | 1 | |||
| Total: | 11 (31%) | 2 (6%) | 10 (29%) | 12 (34%) |
Publisher’s Note: MDPI stays neutral with regard to jurisdictional claims in published maps and institutional affiliations. |
© 2021 by the authors. Licensee MDPI, Basel, Switzerland. This article is an open access article distributed under the terms and conditions of the Creative Commons Attribution (CC BY) license (https://creativecommons.org/licenses/by/4.0/).
Share and Cite
Binimelis-Salazar, J.; Casanova-Katny, A.; Arnold, N.; Lima, C.A.; Norambuena, H.V.; González-Rocha, G.; Palfner, G. Diversity and Host Relationships of the Mycoparasite Sepedonium (Hypocreales, Ascomycota) in Temperate Central Chile. Microorganisms 2021, 9, 2261. https://doi.org/10.3390/microorganisms9112261
Binimelis-Salazar J, Casanova-Katny A, Arnold N, Lima CA, Norambuena HV, González-Rocha G, Palfner G. Diversity and Host Relationships of the Mycoparasite Sepedonium (Hypocreales, Ascomycota) in Temperate Central Chile. Microorganisms. 2021; 9(11):2261. https://doi.org/10.3390/microorganisms9112261
Chicago/Turabian StyleBinimelis-Salazar, Josefa, Angélica Casanova-Katny, Norbert Arnold, Celia A. Lima, Heraldo V. Norambuena, Gerardo González-Rocha, and Götz Palfner. 2021. "Diversity and Host Relationships of the Mycoparasite Sepedonium (Hypocreales, Ascomycota) in Temperate Central Chile" Microorganisms 9, no. 11: 2261. https://doi.org/10.3390/microorganisms9112261
APA StyleBinimelis-Salazar, J., Casanova-Katny, A., Arnold, N., Lima, C. A., Norambuena, H. V., González-Rocha, G., & Palfner, G. (2021). Diversity and Host Relationships of the Mycoparasite Sepedonium (Hypocreales, Ascomycota) in Temperate Central Chile. Microorganisms, 9(11), 2261. https://doi.org/10.3390/microorganisms9112261








